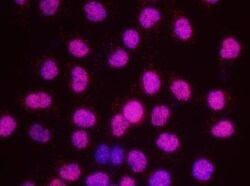

Promotional price valid on web orders only. Your contract pricing may differ. Interested in signing up for a dedicated account number?
Learn More
Learn More
SMC3 Antibody, Novus Biologicals™


Rabbit Polyclonal Antibody has been used in 8 publications
Supplier: Novus Biologicals NB100207
Description
SMC3 Polyclonal specifically detects SMC3 in Human, Mouse, C. elegans samples. It is validated for Western Blot, Immunohistochemistry, Immunoprecipitation, Immunohistochemistry-Paraffin.Specifications
| SMC3 | |
| Polyclonal | |
| Unconjugated | |
| Tris-Citrate/Phosphate (pH 7.0 - 8.0) with 0.09% Sodium Azide | |
| Bamacan, BAMSMC protein 3, Basement membrane-associated chondroitin proteoglycan, BMH, Chondroitin sulfate proteoglycan 6, chondroitin sulfate proteoglycan 6 (bamacan), Chromosome-associated polypeptide, CSPG6structural maintenance of chromosomes protein 3, hCAP, HCAPbamacan, SMC-3, SMC3L1CDLS3, structural maintenance of chromosomes 3 | |
| Rabbit | |
| Affinity Purified | |
| RUO | |
| Primary | |
| Mismatches: Drosophila - 2 (1 conserved, 1 not conserved). Based on 100% sequence identity, this antibody is predicted to react with Panda, Orangutan, Rhesus Monkey, Gorilla, Chimpanzee, Duckbill platypus, Tasmanian devil and White-tufted-ear marmoset. | |
| Store at 4C. Do not freeze. |
| Western Blot, Immunohistochemistry, Immunoprecipitation, Immunohistochemistry (Paraffin) | |
| 1.0 mg/mL | |
| Western Blot 1:10000 - 1:25000, Immunohistochemistry, Immunoprecipitation 2-10 ul/mg, Immunohistochemistry-Paraffin 1:100-1:500 | |
| NP_005436.1 | |
| SMC3 | |
| The immunogen recognized by this antibody maps to a region between residue 1175 and the C-terminus (residue 1217) of human Structural Maintenance of Chromosomes 3 using the numbering given in entry NP_005436.1 (GeneID 9126). | |
| 100 μL | |
| Cancer, Cell Cycle and Replication, Chromatin Research, DNA Repair | |
| 9126 | |
| Human, Mouse | |
| IgG |
Product Content Correction
Your input is important to us. Please complete this form to provide feedback related to the content on this product.
Product Title
For Research Use Only
Spot an opportunity for improvement?Share a Content Correction